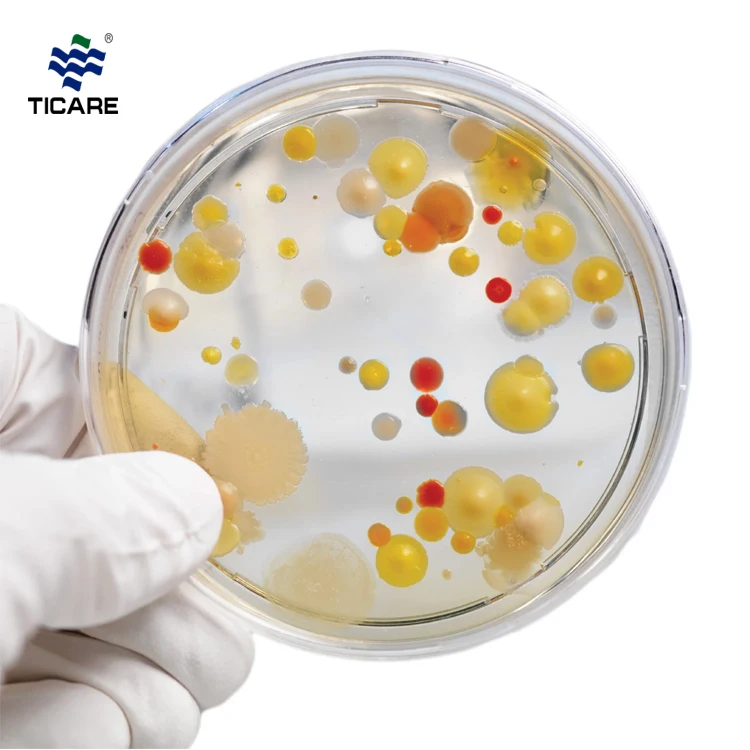
tc7001-agar-2.jpg

Share on (1600604229207):

1. Q: Are you a factory or a trading company?
A: We are a factory and we also is a trading company.
2. Q: How about the MOQ?
A: Different item with different MOQ.
3. Q: Does the sample is free ?
A: With few piece of Disposable Consumable is free.
The Other Items both are not free.
4. Q: Does the express freight is free?
A: The freight is collect!
5. Q:How about the delivery?
A: General,20-25days,According to the number of orders to determine the delivery date.
6. Q: How about the payment term?
A: 1)100% Prepayment for total order amount within $10000.
2)30% prepayment by TT,70% balance paid before shipment for total order amount more than $10000.
7. Q:How to place order?
A: 1) Directly order on Alibaba.com
2) Contact us to send Proforma Invoice .
8. Q: Do you have Paypal account?
A: No ,we don’t.We only accept the payment by T/T,L/C at sight,Western Union,Money Gram.
9 Q: Do you have any certificates?
A: CE&ISO13485
10. Q: What’s your guarantee?
A: 1)Different item with different guarantee.
2)We are always responsibility for our products.
New products from manufacturers at wholesale prices